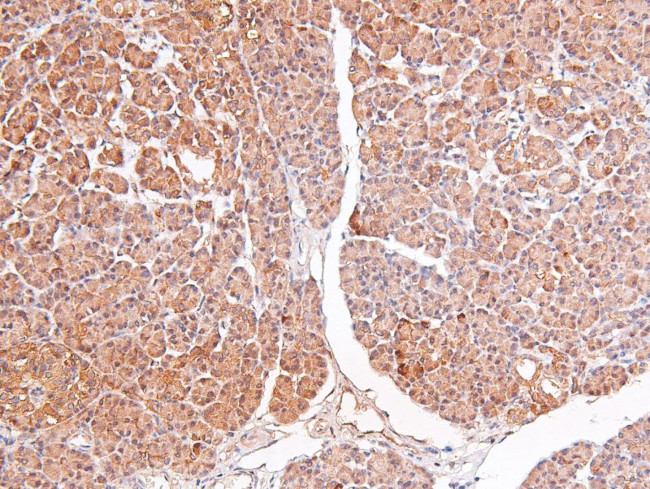
Phospho-RSK3 (Ser360) Antibody in Immunohistochemistry (Paraffin) (IHC (P))

Search
Invitrogen
Phospho-RSK3 (Ser360) Polyclonal Antibody
{{$productOrderCtrl.translations['antibody.pdp.commerceCard.promotion.promotions']}}
{{$productOrderCtrl.translations['antibody.pdp.commerceCard.promotion.viewpromo']}}
{{$productOrderCtrl.translations['antibody.pdp.commerceCard.promotion.promocode']}}: {{promo.promoCode}} {{promo.promoTitle}} {{promo.promoDescription}}. {{$productOrderCtrl.translations['antibody.pdp.commerceCard.promotion.learnmore']}}
图: 1 / 5
Phospho-RSK3 (Ser360) Antibody (PA5-118663) in IHC (P)





产品信息
PA5-118663
宿主/亚型
分类
类型
抗原
偶联物
形式
浓度
保存条件
运输条件
RRID
靶标信息
RPS6KA2 (RSK3) serine/threonine kinase is a member of the ribosomal S6 kinase (RSK) family. It is believed that RPS6KA2 is a signal-transducing intermediate in the cellular response to several growth factors. It is found in many tissues, but in higher levels in lung and skeletal muscle. The p90 ribosomal S6 kinases (RSK)1-4 are downstream members of the extracellular signal-regulated kinase (ERK)/MAPK cascade. The loss of RSK2 activity in humans leads to Coffin-Lowry syndrome, which is characterized by mental retardation and growth deficits and may have a tonic regulation on G-protein coupled signaling.
仅用于科研。不用于诊断过程。未经明确授权不得转售。